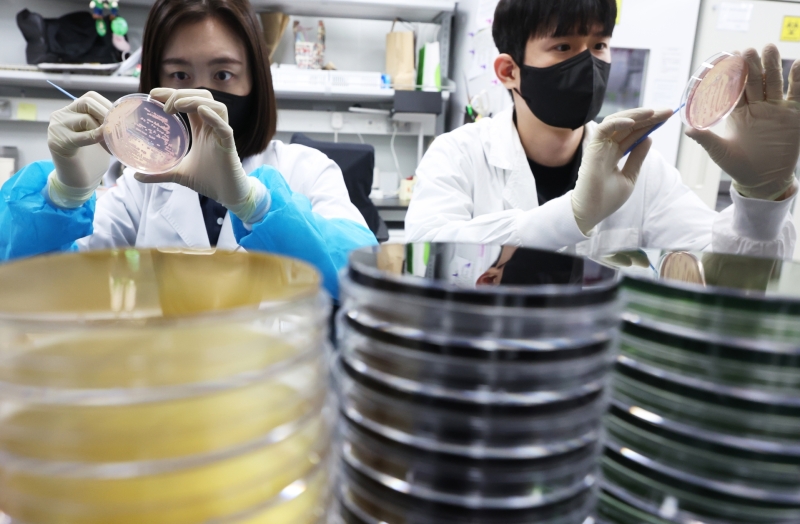

경남 양산과 울산에 위치한 기업체 8곳에서 집단 식중독 의심 증상이 발생해 보건당국이 역학조사에 나섰습니다.
두 지자체는 회야강을 끼고 마주하고 있습니다.
2일 양산 웅상보건소 등에 따르면, 지난달 30일 오전 9시 반쯤 웅상보건소에 식중독 신고가 접수됐습니다.
현재까지 설사, 복통 등 증상으로 병원에 입원한 환자는 49명에 이릅니다.
환자들은 양산시 용당동 기업체 6곳과 울산 울주군 웅촌면 기업체 2곳의 직원인 것으로 파악됐습니다.
보건당국은 환자 대부분이 지난달 27일 용당동 소재 급식업체가 납품한 점심을 먹은 것으로 확인했습니다.
보건당국은 식중독 의심자와 식당 관계자 등 100여 명의 분변과 음식물을 수거해 경남도보건환경연구원에 검사를 의뢰했습니다.
보건소 관계자는 "정확한 원인 규명과 추가 피해 방지를 위해 신속히 조사 중"이라고 밝혔습니다.

























































댓글
(0)